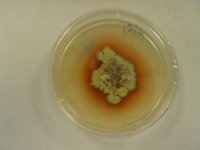
紫膠蟲

簡介
 紫膠蟲
紫膠蟲紫膠蟲是一種重要的資源昆蟲,生活在寄主植物上,吸取植物汁液,雌蟲通過腺體分泌出一種純天然的樹脂—紫膠。紫膠是一種重要的化工原料,廣泛地套用於多種行業。
紫膠蟲寄生於黃檀、山合歡、白背葉、三葉豆和大青樹等多種樹木,每年可繁殖2代,第一代稱為夏代,第二代稱為冬代。夏代喜歡通風陰涼的環境,而冬代則以溫暖和背風向陽的環境為宜。每年一般在4~5月間為夏代的放養期,約經過5個月便可採收紫膠。9~10月是冬代的放養期,第二年的4~5月收膠。剛孵出的若蟲向周圍擴散爬行覓食,一旦固定下來取食,則不再移動。紫膠主要依靠雌蟲分泌,雄蟲分泌很少,此外也分泌紫膠蠟,蠟呈粉狀、絲狀或片狀。紫膠蟲在用口針吸食寄主植物的汁液過程中,常常將多餘的糖分從肛門排出體外,呈露珠狀,味甜,稱為蜜露,常招引螞蟻前來舔食;同時蜜露容易使植物產聖姻煤病,影響寄主植物的正常生長。
生長特徵
紫膠蟲有雌雄之分,變態不同,形態也不一樣。雌蟲為不完全變態,雄蟲為完全變態,雌蟲一生經過卵、幼蟲和成蟲三個階段;雄蟲則要經歷卵、幼蟲、前蛹、真蛹和成蟲五個階段。其形態特徵簡述如下:
 紫膠蟲
紫膠蟲卵:圓形,紫紅色,卵殼薄而透明,一般0.4-0.6mm。
幼蟲:剛孵化的幼蟲似船形。在整個幼蟲期,雌蟲有三個齡期,雄蟲只有兩個齡期。它們的形態是很不相同的。
1.一齡幼蟲雌雄兩性一般難以區分,蟲體長約0.6-0.8mm,寬0.2-0.3mm。體節明顯,分頭、胸、腹三部分。頭部在蟲體前端,有單眼、觸角各一對,口針一個。胸部分三節,有胸 足3對,氣門兩對,腹板一對。前氣門位於中胸,較大;後氣門在後胸,較小。腹板上有蠟腺,分泌白色蠟絲。腹部八節,狹長,末端有肛門一個,肛門四周肛板上有6根肛環剛毛和兩根細長的臀瓣剛毛。
2.二齡幼蟲蟲體較一齡肥大,長0.9mm,寬0.4mm,頭、胸、腹區分不明顯。單眼和臀瓣剛毛消失,觸角和足均已退化,肛環剛毛從一齡時的6根增加到10根。二齡中期和後期,雌雄個體可以用肉眼區分。雌蟲體型較粗短,腹部第三節有背突。雄蟲體形似長筒形,顏色比雌蟲更鮮紅,沒有背突。
3.三齡幼蟲只有雌蟲才出現三齡,蟲體更肥大,長約1.2mm,寬0.8mm,背突明顯。
 紫膠蟲
紫膠蟲前蛹:為雄蟲獨有。長約1.1mm,寬約0.6mm。口器退化,出現觸角和胸足的雛形,透明,短小,不分節。腹部末端肛門消失,有一個陽莖鞘突。有翅型具有一對透明的翅芽。
真蛹:亦為雄蟲所獨有。長1.1~1.8mm,寬0.4~0.5mm,一般較前蛹粗短。但觸角與胸足顯著伸長,而且分節比較明顯,陽莖鞘角質化,淡黃色。有翅型具有一對大翅芽。
成蟲:雌成蟲體形差異較大,有囊形、近球形、紡錘形等。一般長約4.3mm,寬約2.6mm,分節不明顯。頭部有口器一個,口器前後各有口突一對。有單眼兩對,觸角一對。胸部有足三對。胸部有前氣門和後氣門各一對。前氣門位於中胸腹板下方,較大。後氣門位於後胸,較小。前氣門上方有一腹板突起,上生一骨化板叫膊板。板上面著生蠟絲,叫膊板蠟絲。腹部第三節上即原來背突的地方長出一根背刺,這是雌成蟲的重要特徵。腹部末端三節延長成管狀,稱為肛錐,有肛門和生殖孔各一個。肛門周圍有肛環纓和10根肛環剛毛。雄成蟲分有翅型和無翅型兩種。無翅型無翅,體長約1.4mm,寬約0.4mm,比有翅型略小。有翅型在中胸著生一對膜質翅,一般體長約1.7mm,寬0.6mm。有翅或無翅型成蟲均為紫紅色,頭、胸、腹分界明顯。腹部末端有陽莖鞘一個和兩根細長的白蠟絲。
生活習性
紫膠蟲的放養及紫膠的採收:
 紫膠蟲放養
紫膠蟲放養(-)紫膠蟲的放養日時間:原膠產區一般在5月,掛後1~2天幼蟲在早上7~9時涌散固定。此期較高氣溫和直射陽光都不利幼蟲上樹和固定。當種膠運到後,及時選擇晴天早晨掛放。陰雨及大風天氣不能掛放,應把
種膠攤晾在陰涼處以延遲出蟲。目方法:掛前選好寄主樹和應掛的枝幹部位;以生長粗壯位於樹冠的東向、南北向技為好,並掛放在枝的背光面。要綁緊固牢,貼緊不留空隙。因蟲子小,梗與枝間存在很小距離,也會成為膠蟲涌散後上樹的障礙,而只能在梗上擁擠徘徊,直至死亡,導致掛養失敗。所以應使膠梗兩端空技斜面背部緊貼樹幹、枝;若種膠梗不直,可使下端貼緊、上端用一段小樹枝楔滿梗與技間的空隙,起搭橋作用,以利
 放養紫膠蟲的優良寄主
放養紫膠蟲的優良寄主幼蟲通行。膠梗兩端空校與技緊貼後用竹蔑、麻或細繩等綁牢,只綁兩端空技地方。
為保證涌散整齊,採用攤晾養蟲、出蟲掛放,便於掛後管理和採收,也可免除因種膠質量差所造成的掛養失敗。方法是:及時把運到的種膠取出,放在室內或能避風雨的地方;條件是陰涼、乾燥、通風、有光以利出蟲;每日檢查,把已出蟲的膠梗取出掛養,直到出蟲結束。自放蟲量:放蟲量在生產中關係到寄主樹枝條的合理利用和種膠產量高低。如放種量過多,浪費種膠而且影響樹的生長,甚至樹死蟲亡無膠可收;放種量不足,上央少,產膠量低。適當的放蟲量由兩個主要條件決定:一是種膠的質量,一段膠梗能出多少蟲可固定多長
 放養紫膠蟲的優良寄主
放養紫膠蟲的優良寄主的技段;二是寄去樹能負荷多少蟲。種膠質量分為三級,其中一、二級作種膠,“同級種膠因代別和寄主樹不同繁殖量也有差別,例如一級的繁殖量(可以繁殖的倍數),木豆夏代為1:3入冬代1:71;牛肋巴夏代1:3o、冬代1:43;思茅黃檀夏代1:30、冬代1:74。寄主樹的負荷量,根據寄主樹有效校長度來確定,有效技因種
而別,木豆、牛肋巴是1年生枝(乾),其它種是2~3年生枝(乾)。一株樹所有有效校長度相加得有效技總長度,參照寄主樹耐蟲率:木豆夏代為 30~ 40%、冬代 20~ 30%;牛肋巴夏代 50~ 70%、冬代60%;合歡夏代 50~70%,按以下公式計算放蟲量:放養種膠梗長度=有效枝總長*耐蟲率/繁殖量例如1株合歡有效技總長30米,掛放木豆冬代種膠其繁量為1:71,按上式計算,該樹掛放21~29厘米長的一級種膠就夠了,若是二級種膠還應多掛220%左右的種膠梗。園管理:主要工作是三查一收及病蟲防治。三查是在掛後的幾天內逐日逐株檢查,一套膠梗有無鬆動、脫落,如有立即補綁和重掛;二查斜口部位是否緊貼,膠蟲上樹是否順利,如不緊貼可再綁緊和搭橋;三套技放部位和固蟲量是否合適,如部位不當可取下重掛,固蟲量多了應立即解下轉掛在上蟲不足的枝幹上
或其它樹上。以後發現有因蟲過量,樹葉開始翻黃或脫落,要果斷地把已固定部分膠蟲,用草束勒死或竹片刮死,否則樹死蟲亡,一無所獲。及時收回已出完蟲的種膠梗。一般掛放夏代(4~5月)在掛後。~7天,冬代(9~10月)在掛後的8~14天,蟲已出完,取下種梗剝下肢塊,晾乾作原膠出售。若種膠產區黑、白蟲害嚴重,應把取下的種梗及時放入清水中,泡24小時,即可把膠塊里的害蟲全部殺死,取出膠塊晾乾不影響膠的質量。
危害紫膠蟲最大的害蟲,是從自然產區帶來,專食膠蟲和肢被的黑、白蟲。黑蟲屬遮顏蛾科;白蟲又名紫膠白蟲,正名為紫膠獵夜蛾,夜蛾科。防治方法除加強檢疫防止或減少害蟲隨種膠調入外,還可在晾膠養蟲時在有紗窗的室內進行,關好門窗,使羽化的成蟲飛不出去,待種膠掛完後用藥殺死;及時收回種膠殺死害蟲。
寄生於膠被表面的煤煙病和綠霉與膠表蜜需大量凝集和膠林過密。陰濕。通風不良緊密相關。防病的根本在於改善林地衛生和通風條件;病害嚴重時可噴1:1:100的波爾多液或波美0.1'的石硫合劑防治。
(二)紫膠的採收
日種膠的採收:種膠是用於掛放紫膠生產的膠源,只有膠被厚、豐碩連片、顏色正常、鮮技活蟲、無病蟲害的膠梗才能做種膠。就地掛放,當有報信蟲子即可採收,最好隨采隨掛;若在較遠地方掛放,則要有 20%左右的寄主樹有報信蟲子方可大量採收,並在 1~ 2天內運往目的地和掛放完。外調的種膠,不僅量多而且從採收到往掛改地點和完成技放所需天數較多,必須在專門技術人員指導下,有計畫、有目的進行採收。採收又叫砍膠,用鋒利的刀把有膠塊的膠技砍下,陽離膠塊的上下方各約5厘米,口面呈斜形、兩端斜面應同一方向以利掛放。若膠塊只包技的大部分,口面應向著膠厚的一面。種膠集中後放在陰涼通風地方,剪(砍)去兩端的過長空技並逐核檢查質量,再用竹筐包裝,筐高33厘米,底面長45厘米,寬33厘米,四壁網眼直徑3~5厘米。裝時四角放村蔑,分層散放,膠校間有一定空隙,上蓋竹蓋,每包重約25公斤;貼上寫明產地、淨重、採收日期的標籤,及時運往目的地。運輸中保持通風,切忌日曬雨淋和大量堆放。目原膠採收;連枝砍下的膠技,剝下的膠塊就是原膠。
 紫膠蟲的分泌物與殘體
紫膠蟲的分泌物與殘體四川盆地南部地區多在9~10月採收。具體採收應根據膠明顯裂紋,新膠停止增加,蠟絲減少等特徵以及剝開膠塊,孵化腔很明顯,腔中已有幼蟲蠕動,綜合判斷肢蟲已完全成熟方可採收;已有蟲子大量爬出應及時採收。剛採回的鮮膠含有大量水分和待孵的蟲卵、已孵化的蟲子,應及時攤晾在乾燥通風地方,厚度5厘米,便於風乾和蟲子爬出;普遍出蟲後,堆晾厚度可增加到12厘米;每天翻動一次,10天后隔天翻動一次直至全部乾燥。原膠產區氣候較陰濕,晾乾時間約需1月以上前後所采鮮膠混在一起,晾乾時間更長。原膠風乾後,即可裝箱或裝袋,儘早交售或運往加工廠並注意防熱、防潮和通風,以上各個環節不注意都會使原膠質量降低。
 紫膠蟲
紫膠蟲加工:加工工序是:選擇去雜——破碎一一過篩分級——浸泡一一洗滌一一脫水——乾燥一一過篩等,產品為顆粒膠。顆粒膠再經過熔化、壓片等工序,產品為片膠,呈橙黃色或橙紅色、透明、質脆。
養殖管理
放養地和寄主植物
 紫膠蟲
紫膠蟲紫膠蟲性喜溫暖,環境氣候條件的優劣直接影響到放養的成敗。因此放養場地應選擇土地較肥沃、寄主植物生長良好的地方,環境條件是山脈東西走向或北面有高山、南面開闊、背風向陽、冬季有較長日照的坡地,冬暖無霜或僅有輕霜,溫濕條件好。
紫膠蟲一年四季都離不開寄主植物,寄主植物為它提供食料及棲息場所。紫膠蟲寄主植物的種類多達320餘種,其中野生數量較多,產膠量較大,生產上常用的有鈍葉黃檀、南嶺黃檀、木豆、山合歡、大葉千斤拔等30餘種。
選種和接蟲方法
應選擇膠蟲完全成熟、膠被厚、蟲膠連片和無病蟲害的膠枝。要做到適時採種,這是紫膠生產中獲得豐收的關鍵環節,即膠蟲開始涌散才進行採收。採收時用刀將膠種枝兩端砍成斜切口,以便接蟲時若蟲從尖端爬上寄主。
紫膠蟲在南方產區一年可放養2次,4~5月為第一次,9~10月為第二次。接蟲應選擇在無雨晴天的上午或傍晚進行。接蟲時一般先將膠枝砍成20~60厘米長,兩端削成馬蹄形的斜口,再將其用細繩綁紮或釘在放養的寄主樹枝上,若兩端不能同時緊貼樹枝,至少使上端緊貼樹皮,以便若蟲順利爬上枝條固定,如果是黃檀類寄主植物,應把膠枝綁在l~3年生的枝條下方。因為若蟲爬行能力較弱,如果接種到高大的寄主樹上,切不可將膠枝綁在離有效枝條太遠的地方,應儘可能接近1~3年生的有效枝條,以便於若蟲固定生長。
管理接蟲放養2~3天后,應經常檢查固蟲數量是否合適,膠枝是否鬆脫或位置是否適合,必要時加固或作調整。固蟲量合適與否,應視若蟲總體固定的長度占整株樹上直徑為1~3厘米枝條總長度的30%~60%。檢查如發現固蟲量已夠,應將種膠枝移到固蟲量未夠的枝條上。若蟲如已涌散結束,要及時收種膠枝。為了充分發揮寄主樹林的生產潛力,要因時因樹靈活掌握固蟲量,以達到豐收。固蟲量夏代可多些,冬代可少些;大樹可多些,小樹可少些;長勢好的樹可多些,反之則宜少些;耐蟲的樹可多些,反之則宜少些。
放養後應有專人負責,加強管理,否則也容易造成減產或失收。要加強寄主樹管理,搞好對寄主代林的除草、施肥、鬆土,防止在林地放牧牲畜,以免破壞傷害寄主林。
常見病蟲害防治
在紫膠蟲放養生產上,常遇到如下幾種主要的病蟲害。平時要勤檢查,早發現,及時進行防治。
紫膠蟲
紫膠蟲1.紫膠白蟲
白蟲是紫膠的主要害蟲,主要捕食紫膠蟲若蟲和取食部分紫膠,造成若蟲和紫膠的嚴重損失。
防治方法:①一般採用人工捕捉和刺殺法來消滅其成蟲,減少害蟲蟲源;②也可以利用其天敵小繭蜂作生物防治,保護和利用自然天敵,能達到長期控制紫膠白蟲為害的效果。
2.紫膠黑蟲
紫膠黑蟲主要為害、取食貯存的紫膠,也捕食紫膠蟲若蟲。
防治方法:參照紫膠白蟲的防治。
3.黃胸小蜂
黃胸小蜂主要是寄生在紫膠蟲雌蟲體內,對紫膠生產有一定的影響,但目前尚未有較好的防治方法。
 紫膠蟲
紫膠蟲4.青黴病
青黴病在夏代膠被上發現較多,尤其是夏天潮濕高溫、透光不好時,膠被上呈現出青綠、黃白、紅等各種顏色,感病嚴重時,膠蟲大量死亡,造成紫膠減產。
防治方法:①選在通風透光好的山坡地建園,避免在窪地放養。寄主樹的種植保持適度的株行距;②噴灑化學殺菌劑,可選用甲基托布津、代森鋅、福美雙可濕性粉劑等。
5.煙煤病
煙煤病的發生是由於紫膠蟲排泄大量的蜜露,導致煙煤病菌在膠被上快速地生長蔓延,開始時呈現青綠色,以後顏色逐漸加深,最後變成灰黑色,菌體的堆積阻礙膠蟲的排泄和呼吸,嚴重時導致紫膠蟲大量死亡而影響產量。
防治方法:藥劑防治可選用乙磷鋁、代森鋅或退菌特噴霧防治。
經濟價值
紫膠蟲分泌的原膠稱為紫膠(或稱蟲膠),紫膠含三種主要化學成分,其中樹脂占65%~80%,蠟占4%~8%,紫膠色素、水分等占2%~7%。紫膠原膠可直接人藥,中國古代已在醫學上套用,使用範圍很廣,它具有清熱去濕,涼血、解毒作用,臨床上主治麻疹、斑疹、產後血暈等多種疾病,對疥瘡、經血不止和牙齦出血也有一定療效。紫膠也可用作中、西藥丸、藥片的包衣,以防止藥物受潮變質。紫膠還具有絕緣、防水、防鏽、防紫外線、粘合性強、表面光滑、易乾、耐酸、耐油、化學性能穩定、對人無毒和無刺激性等優良性能,從而被廣泛用於軍事、電氣、橡膠、油墨、機械、食品等工業作為原料或塗料。總之,紫膠用途廣闊,紫膠生產有著廣闊的發展前景,有很高的經濟價值。
 紫膠蟲
紫膠蟲紫膠蟲為中國重要資源昆蟲之一,它在寄主樹上繁殖生長而分泌出來的天然樹脂。其色紫紅,稱紫膠(亦稱“蟲膠”)紫膠樹脂產品可用作中西藥藥片、藥丸的包衣、它能防止藥品的潮解變質。紫膠蟲樹上所分泌的膠質入藥,套用範圍廣,有清熱、涼血、解毒功能,臨床上主治麻疹、斑疹不易透發、產後血暈等病症。此外,紫膠還是重要的工業原料,常用作塗料、絕緣體、油墨等。
中國紫膠產區比較廣闊,寄生植物種類繁多、資源豐富。可以利用紫膠蟲“生長”的地區大量發展紫膠生產。
加工
原膠可以根據不同用襖進行再加工。
(1)去色、去雜質加毛:可將膠粒放人水盆等容器,清水浸泡,用木棒反覆攪拌、邊撈去浮起的木屑等雜物,同時換水再漂洗直到雜質去淨、然後將膠粒曬乾或置室內通風處攤開晾乾,即成顆粒膠。
(2)加工蟲膠片:若要將膠粒加工成片膠,可以將膠粒用熱蒸汽加熱溶化,過壓片機壓制即成。
(3)蟲膠漆的製作:將片膠或膠粒按一定的比例加人95%的工業酒精,於密封的玻璃瓶內浸泡5~7天,即可作收乾型油漆使用或作他用。
藥物利用
紫膠蟲也是一種資源昆蟲。中國古書中曾把紫膠稱為赤膠(張勃:《吳錄》265—289)、紫鉚(蘇恭:《唐新修本草》659)、紫吁(李時珍)、紫梗(周達觀:《真臘風土記》,1328),一直到了餘慶遠著《維西見聞紀》(1765),才用紫膠這個名稱。
紫膠首先是用作藥材,其次用作染料。張勃、蘇恭都有用作染料的記載,《吳錄》說紫膠可以染絮物(即絲織品);蘇恭說可以染麖皮和寶鈿。蘇頌著《本草圖經》(1061)說今醫方亦罕用,惟染家所需,說明到了宋代紫膠用作染料,已超過藥用了。
中國古代所用紫膠,可能多從國外進口,如《吳錄》所載,紫膠的產地是九真移風果,即今越南中部的清化省。《酉陽雜俎》所載產地為真臘、波斯、崑崙三國。唐代末年李殉著《海藥本草》中引裴淵《廣州志》指出產海南;蘇頌根據《交州地誌》說交州亦為產地之一;李時珍說產南番。雖然都提到了中國也出產紫膠,但可能由於陸上交通不便,不如海路來得方便而從國外進口。《徐霞客遊記》(徐宏祖,1650)才第一個人明確雲南省是中國紫膠的產地,一直到現在雲南省仍然是中國紫膠的主要產區。過去雲南省所產的紫膠都以低價作為原料輸出國外,在國際市場上占相當數量。
近代由於受到帝國主義的侵略,中國紫膠自1930年前後生產逐漸停滯,到1945年生產完全停頓,種膠幾乎斷絕。中國解放後,經過努力,紫膠生產才逐漸恢復。
昆蟲百科
| 昆蟲是動物界中最大的一個類群,無論是個體數量、生物數量、種類與基因數,它們在生物多樣性中都占有十分重要的地位。昆蟲與人類的關係複雜而密切,有些昆蟲給人類造成深重的災難,有些種類給人類提供了豐富的資源。 昆蟲綱Insecta是動物界中最大的一個綱。 |

